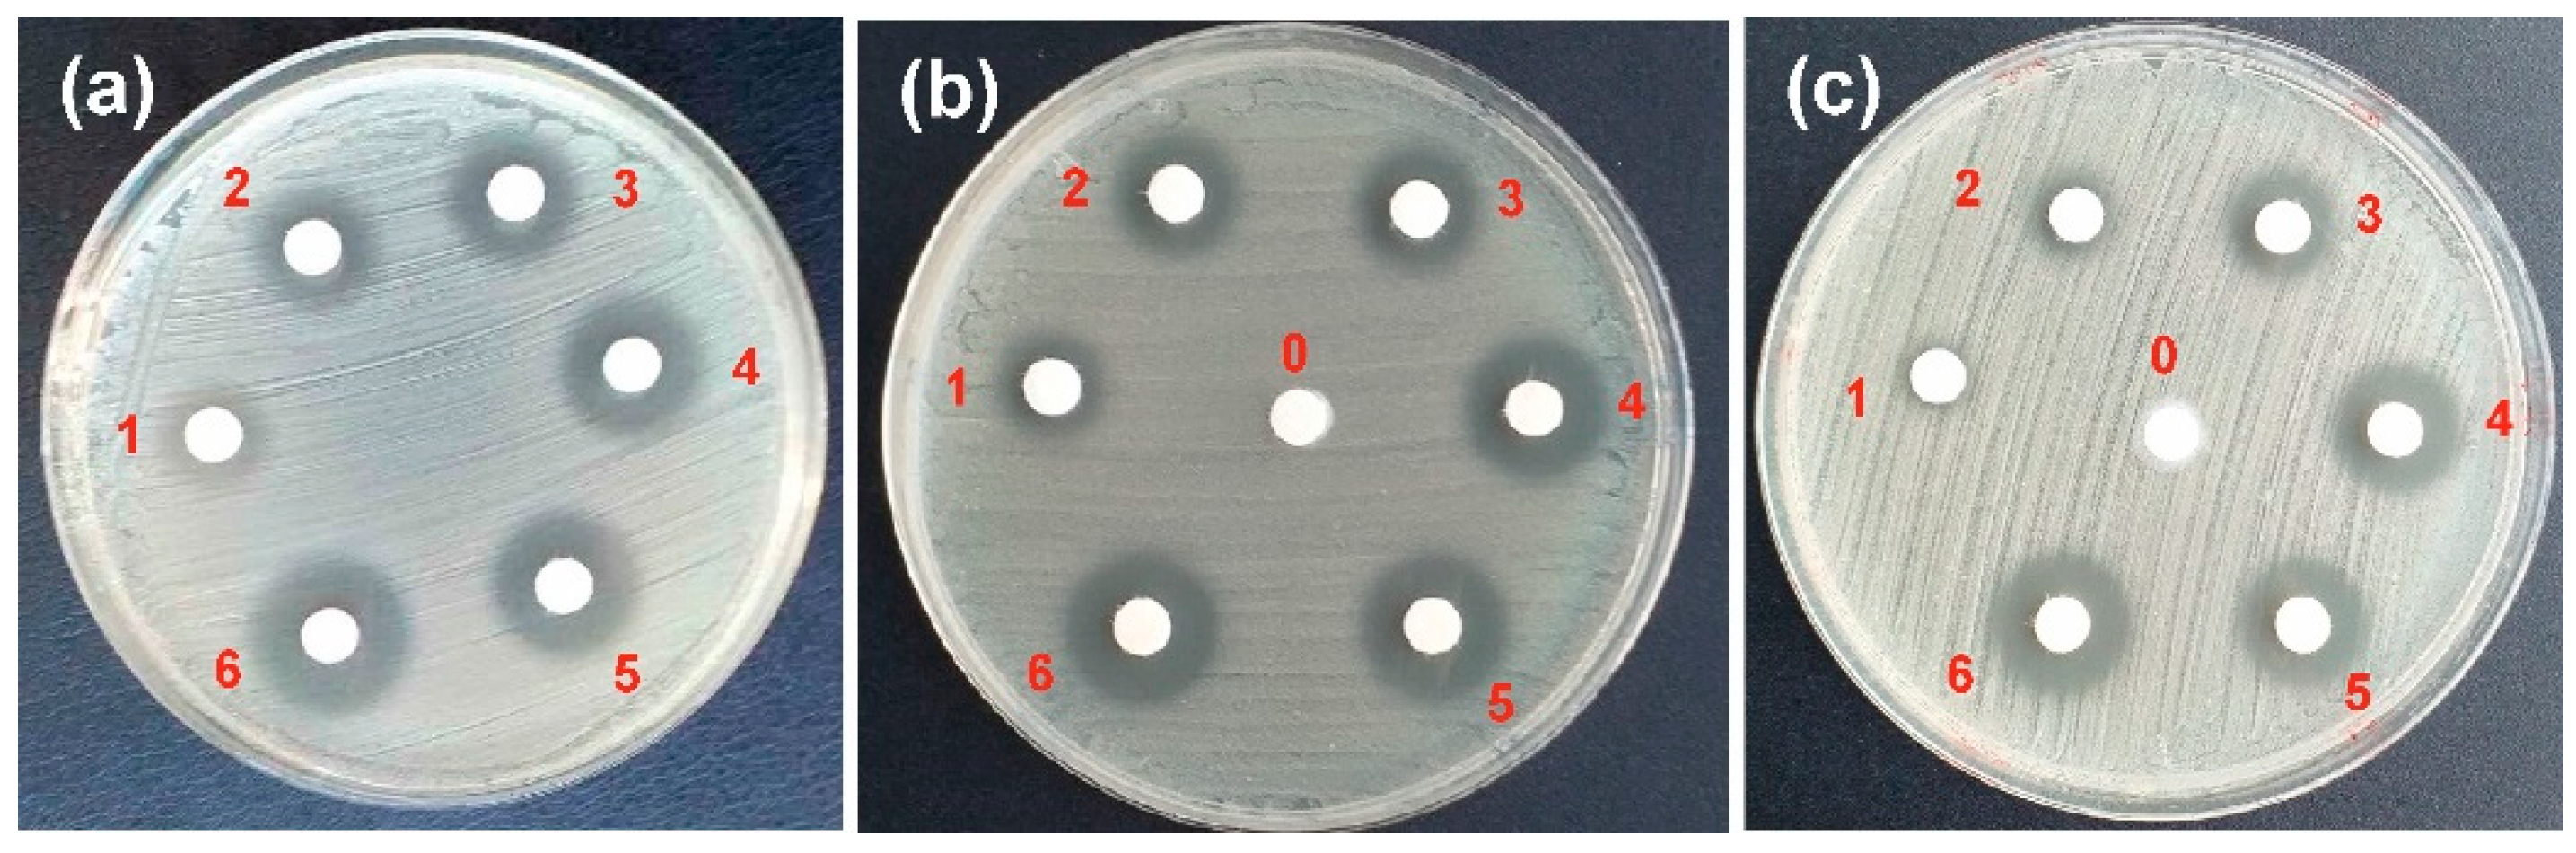

Clindamycin-Loaded Halloysite Nanotubes as the Antibacterial Component of Composite Hydrogel for Bone Repair
Abstract
1. Introduction
2. Materials and Methods
2.1. Materials
2.2. Etching of Halloysite Nanotubes
2.3. Loading of CP into the HNT or EHNT
2.4. Hydrogel Preparation
2.4.1. Preparation of Hydrogel H1-EDC/CaCl2
2.4.2. Preparation of Hydrogel H2-CACl2/EDC
2.5. Studies of the CP Release
2.5.1. Release from the Nanotubes (HNT-CP and EHNT-CP)
2.5.2. Release from H1-EDC/CaCl2 and H2-CACl2/EDC Hydrogels
2.6. Degradation Studies
2.7. Biomineralization Studies
2.8. SEM Measurements
2.9. TEM Measurements
2.10. Antibacterial Tests
2.11. MTT Test
2.12. SEM Studies of the Cells’ Morphology on Hydrogels
2.13. Other Measurements
3. Results and Discussion
3.1. Bioactive EHNT-CP System
3.1.1. Pre-Treatment and Drug Loading of Halloysite Nanotubes
3.1.2. Studies of CP Release from HNT and EHNT Nanotubes
3.1.3. Antibacterial Properties of HNT-CP and EHNT-CP
3.2. Bioactive Alginate-Based Hydrogels
3.2.1. Morphology and Porosity of the Hydrogels
3.2.2. Drug Release from Hydrogels
3.2.3. Swelling and Degradation Studies
3.2.4. Antibacterial Activity of the Hydrogels
3.2.5. Biomineralization Studies
3.2.6. Biological Studies of the Bioactive Hydrogels
4. Conclusions
Supplementary Materials
Author Contributions
Funding
Institutional Review Board Statement
Data Availability Statement
Conflicts of Interest
References
- Dong, C.; Lv, Y. Application of Collagen Scaffold in Tissue Engineering: Recent Advances and New Perspectives. Polymers 2016, 8, 42. [Google Scholar] [CrossRef] [PubMed]
- Nudelman, F.; Lausch, A.J.; Sommerdijk, N.A.J.M.; Sone, E.D. In vitro models of collagen biomineralization. J. Struct. Biol. 2013, 183, 258–269. [Google Scholar] [CrossRef] [PubMed]
- Graulus, G.J.; Mignon, A.; Van Vlierberghe, S.; Declercq, H.; Fehér, K.; Cornelissen, M.; Martins, J.C.; Dubruel, P. Cross-linkable alginate-graft-gelatin copolymers for tissue engineering applications. Eur. Polym. J. 2015, 72, 494–506. [Google Scholar] [CrossRef]
- Gilarska, A.; Lewandowska-Łańcucka, J.; Guzdek-Zając, K.; Karewicz, A.; Horak, W.; Lach, R.; Wójcik, K.; Nowakowska, M. Bioactive yet antimicrobial structurally stable collagen/chitosan/lysine functionalized hyaluronic acid—Based injectable hydrogels for potential bone tissue engineering applications. Int. J. Biol. Macromol. 2020, 155, 938–950. [Google Scholar] [CrossRef]
- Gomez-Florit, M.; Pardo, A.; Domingues, R.M.A.; Graca, A.L.; Babo, P.S.; Reis, R.L.; Gomes, M.E. Molecules. Molecules 2020, 25, 5858. [Google Scholar] [CrossRef]
- Qin, L.; Yi, J.; Xuefei, L.; Li, L.; Kenan, X.; Lu, X. The preparation of a difunctional porous b—Tricalcium phosphate sca ff old with excellent compressive strength and antibacterial properties. RSC Adv. 2020, 10, 28397–28407. [Google Scholar] [CrossRef]
- Diogo, G.S.; Gaspar, V.M.; Serra, I.R.; Fradique, R.; Correia, I.J. Manufacture of β-TCP/alginate scaffolds through a Fab@home model for application in bone tissue engineering. Biofabrication 2014, 6, 025001. [Google Scholar] [CrossRef]
- Barradas, A.M.C.; Yuan, H.; van Blitterswijk, C.A.; Habibovic, P. Osteoinductive biomaterials: Current knowledge of properties, experimental models and biological mechanisms. Eur. Cell Mater. 2011, 21, 407–429. [Google Scholar] [CrossRef]
- Daskalakis, E.; Huang, B.; Vyas, C.; Acar, A.A.; Fallah, A.; Cooper, G.; Weightman, A.; Koc, B.; Blunn, G.; Bartolo, P. Novel 3D Bioglass Scaffolds for Bone Tissue Regeneration. Polymers 2022, 14, 445. [Google Scholar] [CrossRef]
- Yang, G.H.; Yeo, M.G.; Choi, E.; Kang, D.; Kim, M.; Nam, Y.; Gwak, S.J.; Yoo, H.H.; Park, M.J.; Jung, B.; et al. Investigating the physical characteristics and cellular interplay on 3D-printed scaffolds depending on the incorporated silica size for hard tissue regeneration. Mater. Des. 2021, 207, 109866. [Google Scholar] [CrossRef]
- Krajcer, A.; Klara, J.; Horak, W.; Lewandowska-Łańcucka, J. Bioactive injectable composites based on insulin-functionalized silica particles reinforced polymeric hydrogels for potential applications in bone tissue engineering. J. Mater. Sci. Technol. 2022, 105, 153–163. [Google Scholar] [CrossRef]
- Fakhrullin, R.F.; Lvov, Y.M. Halloysite clay nanotubes for tissue engineering. Nanomedicine 2016, 11, 2243–2246. [Google Scholar] [CrossRef] [PubMed]
- Pietraszek, A.; Ledwójcik, G.; Lewandowska-Łańcucka, J.; Horak, W.; Lach, R.; Łatkiewicz, A.; Karewicz, A. Bioactive hydrogel scaffolds reinforced with alkaline-phosphatase containing halloysite nanotubes for bone repair applications. Int. J. Biol. Macromol. 2020, 163, 1187–1195. [Google Scholar] [CrossRef] [PubMed]
- Vergaro, V.; Abdullayev, E.; Lvov, Y.M.; Zeitoun, A.; Cingolani, R.; Rinaldi, R.; Leporatti, S. Cytocompatibility and Uptake of Halloysite Clay Nanotubes. Biomacromolecules 2010, 11, 820–826. [Google Scholar] [CrossRef]
- Fakhruddin, K.; Hassan, R.; Umar, M.; Khan, A.; Naula, S.; Izwan, S.; Razak, A.; Hussni, M.; Fitri, H.; Latip, M.; et al. Halloysite nanotubes and halloysite-based composites for biomedical applications. Arab. J. Chem. 2021, 14, 103294. [Google Scholar] [CrossRef]
- Naumenko, E.A.; Guryanov, I.D.; Yendluri, R.; Lvov, Y.M.; Fakhrullin, R.F. Clay nanotube-biopolymer composite scaffolds for tissue engineering. Nanoscale 2016, 8, 7257–7271. [Google Scholar] [CrossRef]
- Same, S.; Kadkhoda, J.; Navidi, G.; Abedi, F.; Aghazadeh, M.; Milani, M.; Akbarzadeh, A.; Davaran, S. The fabrication of halloysite nanotube-based multicomponent hydrogel scaffolds for bone healing. J. Appl. Biomater. Funct. Mater. 2022, 20, 22808000221111875. [Google Scholar] [CrossRef]
- Huang, K.; Ou, Q.; Xie, Y.; Chen, X.; Fang, Y.; Huang, C.; Wang, Y.; Gu, Z.; Wu, J. Halloysite Nanotube Based Scaffold for Enhanced Bone Regeneration. ACS Biomater. Sci. Eng. 2019, 5, 4037–4047. [Google Scholar] [CrossRef]
- Zheng, Z.; Yin, W.; Zara, J.N.; Li, W.; Kwak, J.; Mamidi, R.; Lee, M.; Siu, R.K.; Ngo, R.; Wang, J.; et al. The use of BMP-2 coupled—Nanosilver-PLGA composite grafts to induce bone repair in grossly infected segmental defects. Biomaterials 2010, 31, 9293–9300. [Google Scholar] [CrossRef]
- Zhang, J.; Wang, F.; Yalamarty, S.S.K.; Filipczak, N.; Jin, Y.; Li, X. Nano Silver-Induced Toxicity and Associated Mechanisms. Int. J. Nanomed. 2022, 17, 1851–1864. [Google Scholar] [CrossRef]
- Tan, H.; Ma, R.; Lin, C.; Liu, Z.; Tang, T. Quaternized chitosan as an antimicrobial agent: Antimicrobial activity, mechanism of action and biomedical applications in orthopedics. Int. J. Mol. Sci. 2013, 14, 1854–1869. [Google Scholar] [CrossRef] [PubMed]
- Patel, S.; Jammalamadaka, U.; Sun, L.; Tappa, K.; Mills, D.K. Sustained release of antibacterial agents from doped halloysite nanotubes. Bioengineering 2016, 3, 1. [Google Scholar] [CrossRef] [PubMed]
- Same, S.; Navidi, G.; Samee, G.; Abedi, F.; Aghazadeh, M.; Milani, M.; Akbarzadeh, A.; Davaran, S. Gentamycin-loaded Halloysite-based Hydrogel Nanocomposites for Bone Tissue Regeneration: Fabrication, Evaluation of the Antibacterial Activity and Cell Response. Biomed. Mater. 2022, 17, 065018. [Google Scholar] [CrossRef]
- Avani, F.; Damoogh, S.; Mottaghitalab, F.; Karkhaneh, A.; Farokhi, M. Vancomycin loaded halloysite nanotubes embedded in silk fibroin hydrogel applicable for bone tissue engineering. Int. J. Polym. Mater. Polym. Biomater. 2020, 69, 32–43. [Google Scholar] [CrossRef]
- Neut, D.; Erik, P.; de Groot, R.; Kowalski, S.Z.; Jim, R.; van Horn, H.C.; van der Mei, H.J.B. Gentamicin-loaded bone cement with clindamycin or fusidic acid added: Biofilm formation and antibiotic. J. Biomed. Mater. Res. Part A 2005, 73, 165–170. [Google Scholar] [CrossRef]
- Mohajerani, H.; Irajian, G.; Latifi, F.; Masjedian, F.; Tabrizi, R. Efficacy of low-dose local clindamycin in different times for microbial decontamination of autogenous particulate bone graft. Int. J. Implant. Density 2020, 6, 70. [Google Scholar] [CrossRef]
- Naal, F.D.; Salzmann, G.M.; von Knoch, F.; Tuebel, J.; Diehl, P.; Gradinger, R.; Schauwecker, J. The effects of clindamycin on human osteoblasts in vitro. Arch. Orthop. Trauma Surg. 2008, 128, 317–323. [Google Scholar] [CrossRef]
- Leonidou, A.; Kiraly, Z.; Gality, H.; Apperley, S.; Vanstone, S.; Woods, D.A. The effect of the timing of antibiotics and surgical treatment on infection rates in open long-bone fractures: A 6-year prospective study after a change in policy. Strateg. TRAUMA LIMB Reconstr. 2014, 9, 167–171. [Google Scholar] [CrossRef]
- Gogia, J.S.; Meehan, J.P.; Di Cesare, P.E.; Jamali, A.A. Local Antibiotic Therapy in Osteomyelitis. Semin. Plast. Surg. 2009, 23, 100–107. [Google Scholar] [CrossRef]
- Kokubo, T.; Kushitani, H.; Sakka, S.; Kitsugi, T.; Yamamuro, T. Solutions able to reproduce in vivo surface-structure changes in bioactive glass-ceramic A-W3. J. Biomed. Mater. Res. 1990, 24, 721–734. [Google Scholar] [CrossRef]
- Dudzik, P.; Dulińska-Litewka, J.; Wyszko, E.; Jędrychowska, P.; Opałka, M.; Barciszewski, J.; Laidler, P. Effects of kinetin riboside on proliferation and proapoptotic activities in human normal and cancer cell lines. J. Cell Biochem. 2011, 212, 2115–2124. [Google Scholar] [CrossRef] [PubMed]
- Karnas, K.; Strączek, T.; Kapusta, C.; Lekka, M.; Dulińska-Litewka, J.; Karewicz, A. Specific Binding of Novel SPION-Based System Bearing Anti-N-Cadherin Antibodies to Prostate Tumor Cells. Int. J. Nanomed. 2021, 16, 6537–6552. [Google Scholar] [CrossRef] [PubMed]
- Filipowska, J.; Lewandowska-Łańcucka, J.; Gilarska, A.; Niedźwiedzki, Ł.; Nowakowska, M. In vitro osteogenic potential of collagen/chitosan-based hydrogels-silica particles hybrids in human bone marrow-derived mesenchymal stromal cell cultures. Int. J. Biol. Macromol. 2018, 113, 692–700. [Google Scholar] [CrossRef] [PubMed]
- Garcia-garcia, D.; Ferri, J.M.; Ripoll, L.; Lopez-Martinez, J.; Balart, R. Characterization of selectively etched halloysite nanotubes by acid treatment. Appl. Surf. Sci. 2017, 422, 616–625. [Google Scholar] [CrossRef]
- Pietraszek, A.; Karewicz, A.; Widnic, M.; Lachowicz, D.; Gajewska, M.; Bernasik, A.; Nowakowska, M. Halloysite-alkaline phosphatase system—A potential bioactive component of sca ff old for bone tissue engineering. Colloids Surf. B Biointerfaces 2019, 173, 1–8. [Google Scholar] [CrossRef] [PubMed]
- Tivadar, A. Physico-chemical characterisation of different clindamycin phosphate samples. Bosn. J. Basic Med. Sci. 2007, 7, 182–189. [Google Scholar]
- Ran, Y.; Dong, W.; Wu, S.; Wang, J.; Gong, J. Transformations among the New Solid-State Forms of Clindamycin Phosphate. Org. Process Res. Dev. 2013, 17, 1445–1450. [Google Scholar] [CrossRef]
- Falcón, J.M.; Sawczen, T.; Aoki, I.V. Dodecylamine-loaded halloysite nanocontainers for active anticorrosion coatings. Front. Mater. 2015, 2, 69. [Google Scholar] [CrossRef]
- Urruela-Barrios, R.; Ramírez-Cedillo, E.; de León, A.D.; Alejandro, J.; Alvarez, W.O.-L. Alginate/Gelatin Hydrogels Reinforced with TiO2 and β-TCP Fabricated by Microextrusion-based Printing for Tissue Regeneration. Polymers 2019, 11, 457. [Google Scholar] [CrossRef]
- Luisa, M.; Prado, D.; Karina, K.; Lizárraga, G.; Mauricio, D.; Gómez, G.; Hernández, H.M.; Fuentes, N.R.; Eliú, A.; Rodriguez, C.; et al. Development of collagen-EDC scaffolds for skin tissue engineering: Physicochemical and biological characterization. Int. J. Eng. Res. Sci. 2016, 2, 73–83. [Google Scholar]
- McConnell, D. Crystal chemistry of hydroxyapatite. Its relation to bone mineral. Arch. Oral Biol. 1965, 10, 421–431. [Google Scholar] [CrossRef] [PubMed]
- Edmund, D.P.; Robert, M. Bilyz Bone Carbonate and the Ca to P Molar ratio. Nature 1968, 219, 1261–1262. [Google Scholar]
- Salma, K.; Borodajenko, N.; Plata, A.; Berzina-Cimdina, L.; Stunda, A. Fourier transform infrared spectra of technologically modified calcium phosphates. IFMBE Proc. 2008, 20, 68–71. [Google Scholar]
- Barot, T.; Rawtani, D.; Kulkarni, P. Physicochemical and biological assessment of silver nanoparticles immobilized Halloysite nanotubes-based resin composite for dental applications. Heliyon 2020, 6, e03601. [Google Scholar] [CrossRef] [PubMed]

| Sample Number | Weight of CP (Solution) [mg] | HNT-CP | EHNT-CP | ||
|---|---|---|---|---|---|
| Sample Weight [mg] | CP Weight in the Sample [mg] | Sample Weight [mg] | CP Weight in the Sample [mg] | ||
| 1 | 0.0250 | 0.2500 | 0.0131 | 0.2500 | 0.0138 |
| 2 | 0.0375 | 0.3750 | 0.0197 | 0.3750 | 0.0207 |
| 3 | 0.0500 | 0.5000 | 0.0262 | 0.5000 | 0.0276 |
| 4 | 0.0625 | 0.6250 | 0.0327 | 0.6250 | 0.0345 |
| 5 | 0.0750 | 0.7500 | 0.0393 | 0.7500 | 0.0414 |
| 6 | 0.1000 | 1.0000 | 0.0524 | 1.0000 | 0.0553 |
Publisher’s Note: MDPI stays neutral with regard to jurisdictional claims in published maps and institutional affiliations. |
© 2022 by the authors. Licensee MDPI, Basel, Switzerland. This article is an open access article distributed under the terms and conditions of the Creative Commons Attribution (CC BY) license (https://creativecommons.org/licenses/by/4.0/).
Share and Cite
Machowska, A.; Klara, J.; Ledwójcik, G.; Wójcik, K.; Dulińska-Litewka, J.; Karewicz, A. Clindamycin-Loaded Halloysite Nanotubes as the Antibacterial Component of Composite Hydrogel for Bone Repair. Polymers 2022, 14, 5151. https://doi.org/10.3390/polym14235151
Machowska A, Klara J, Ledwójcik G, Wójcik K, Dulińska-Litewka J, Karewicz A. Clindamycin-Loaded Halloysite Nanotubes as the Antibacterial Component of Composite Hydrogel for Bone Repair. Polymers. 2022; 14(23):5151. https://doi.org/10.3390/polym14235151
Chicago/Turabian StyleMachowska, Adrianna, Joanna Klara, Gabriela Ledwójcik, Kinga Wójcik, Joanna Dulińska-Litewka, and Anna Karewicz. 2022. "Clindamycin-Loaded Halloysite Nanotubes as the Antibacterial Component of Composite Hydrogel for Bone Repair" Polymers 14, no. 23: 5151. https://doi.org/10.3390/polym14235151
APA StyleMachowska, A., Klara, J., Ledwójcik, G., Wójcik, K., Dulińska-Litewka, J., & Karewicz, A. (2022). Clindamycin-Loaded Halloysite Nanotubes as the Antibacterial Component of Composite Hydrogel for Bone Repair. Polymers, 14(23), 5151. https://doi.org/10.3390/polym14235151







